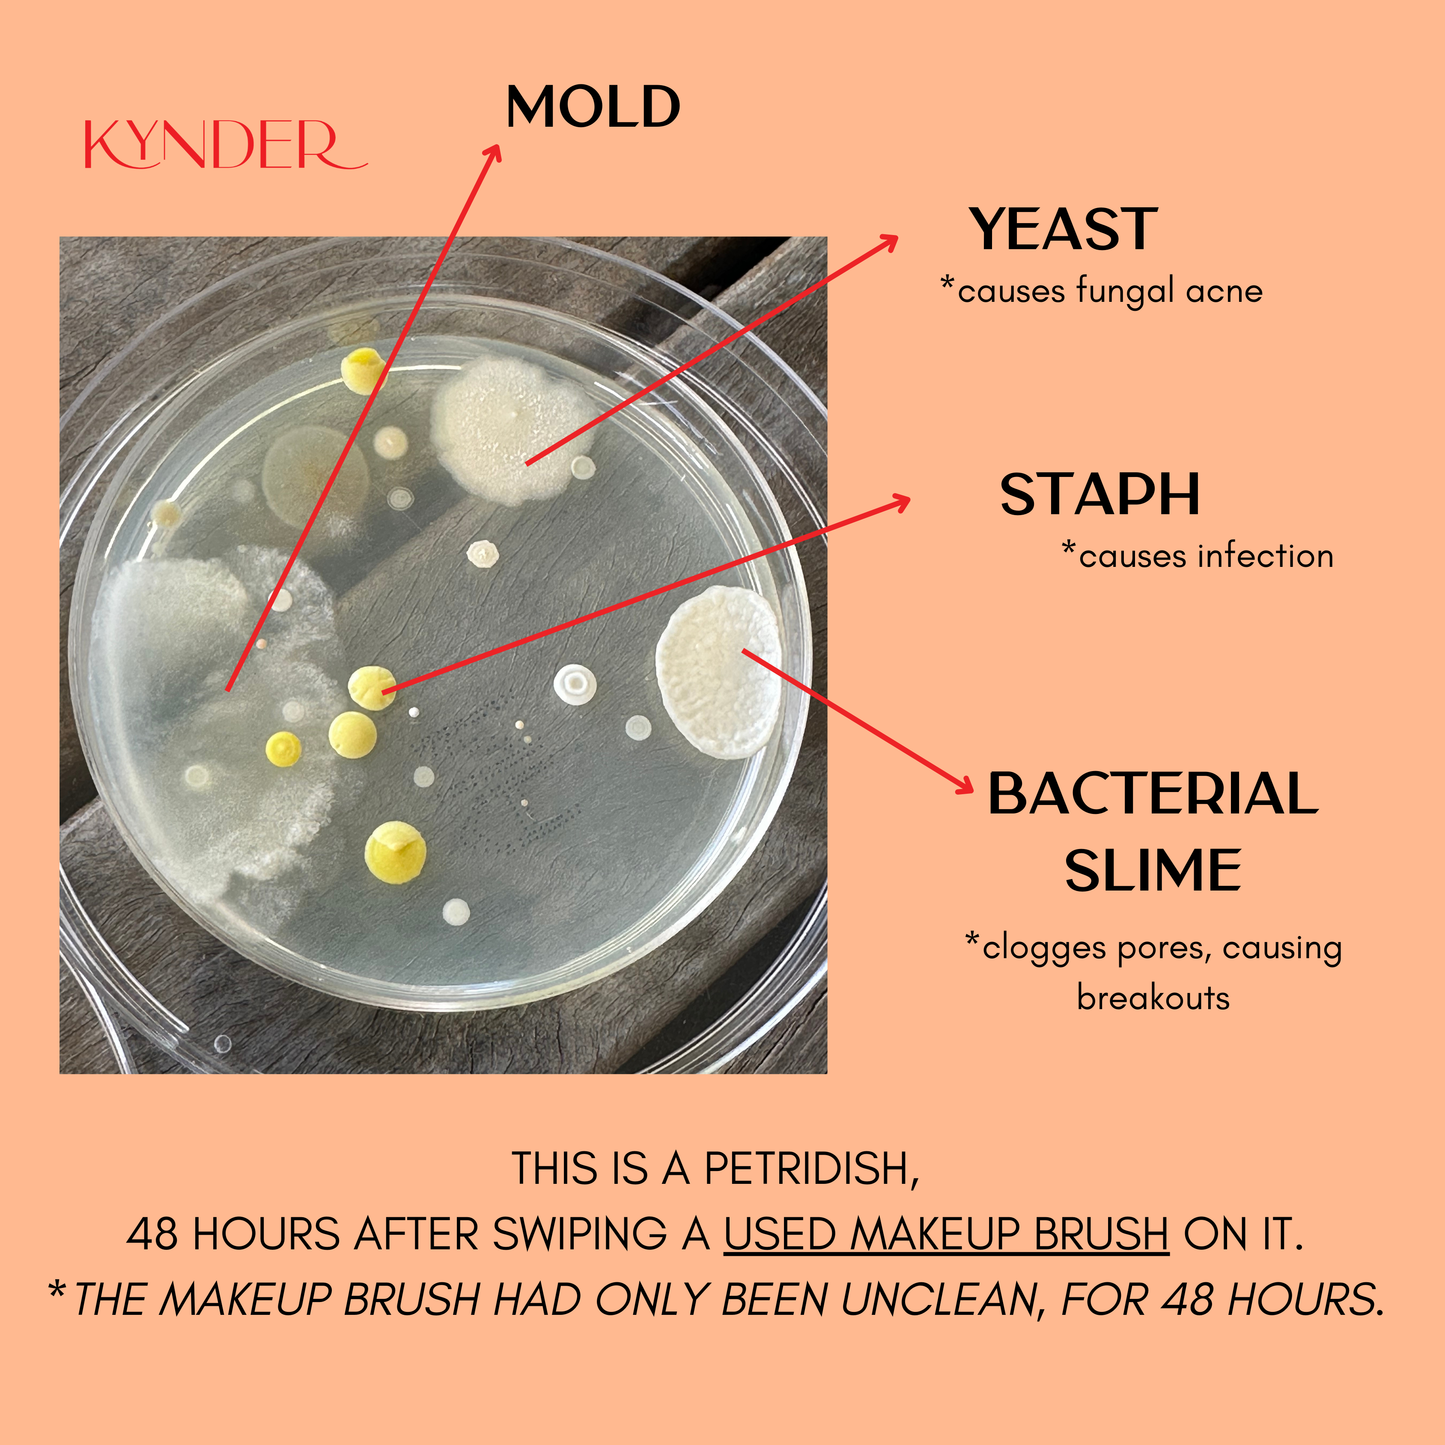
Fresh Start Trio! *Best Value*

KYNDER
Fresh Start Trio! *Best Value* Pre Order (Ships August)
Fresh Start Trio! *Best Value* Pre Order (Ships August)
Couldn't load pickup availability
THE WHOLE COLLECTION SAVING YOU DOLLARS AS WELL AS YOUR SKIN.
You asked, so we listened. Meet ULTIMATE Brush Cleaning Bundle You Need - The whole COLLECTION - Everything you need for perfect makeup, skin and brushes, everytime. Oh, we should probably mention you're getting so much value in this bundle.
So whats included?
3 Brush Defences; stock up on your favourite scents and be well prepared for deliciously smelling makeup brushes, clearer skin and better makeup.
1 Base Towel; for the perfect tool to clean and protect your beauty brushes, ready for the next use.
Our Brush Defence and Base Towel are like two peas in a pod, the perfect match, the bestest of beauty pals... you know where we're going with this.
Our microfibres in our Base Towel were specifically design to help exfoliate your brush bristles and remove the product build up. Simply spritz your Brush Defence onto your Base Towel and swipe back and forth until your brush is clean. Wash your Base Towel with warm water and soap, allow to air dry and she'll be brand new when you need her next. We added a second to use to remove your makeup with just warm water.
Ships 20th of Sept 24 as Peach Iced Tea is currently on Pre-Order. If you'd like your items shipped seperately, contact us on info@kynder.com.au and we can make that happen for you.
Brush Defence: 100ml
Towel measurements: 35cm x 17cm
100% Polyester
Vegan
Distributed by Kynder